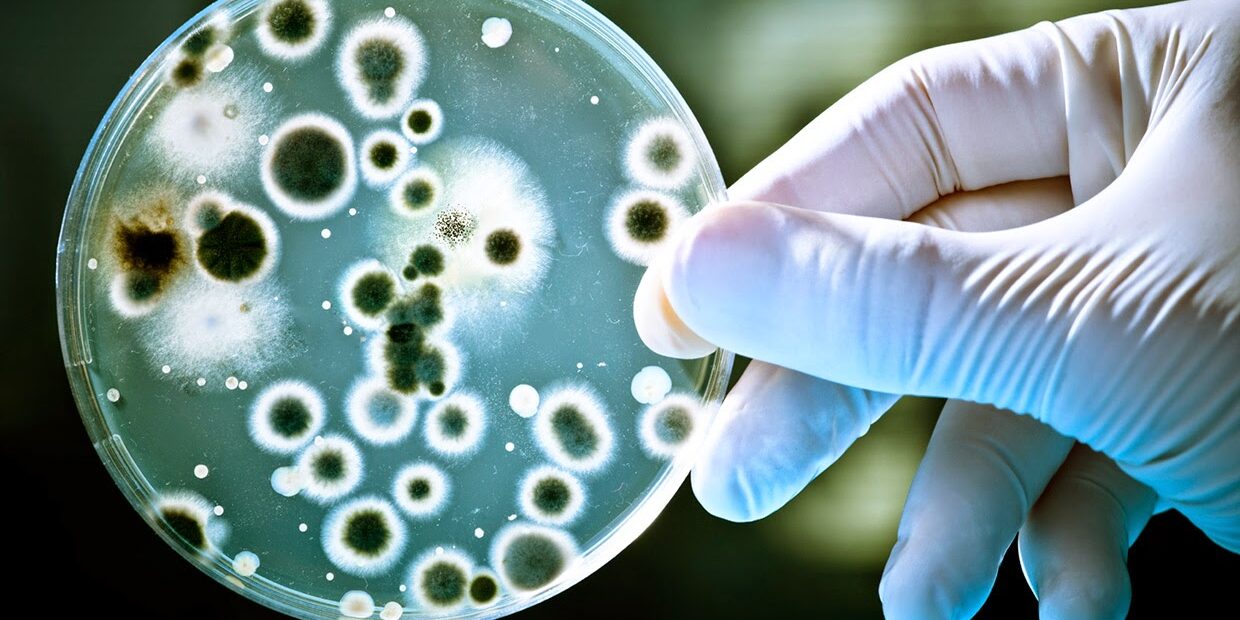

เชื้อรา
เราอาจเรียกอีกอย่างว่า อาณาจักรเห็ดรา สิ่งมีชีวิตที่อยู่ในอาณาจักรฟังไจ ประกอบด้วย รา เห็ด และยีสต์
ลักษณะของสิ่งมีชีวิตในอาณาจักรฟังไจ
1. เซลล์เป็นแบบ Eucaryotic cell มีเยื่อหุ้มนิวเคลียส
2. ไม่มีคลอโรฟิลล์ ดำรงชีวิตเป็นผู้ย่อยสลายสารอินทรีย์ที่เน่าเปื่อย
3. ผนังเซลล์เป็นสารไคตินกับเซลลูโลส
4. มีทั้งเซลล์เดียวและเป็นเส้นใยเล็ก เรียกว่าไฮฟา (Hypha) รวมกลุ่ม เรียกว่าขยุ้มรา (mycelium) ลักษณะของเส้นใยแบ่งออกเป็น 2 ชนิด
4.1 เส้นใยมีผนังกั้น (Septate hypha)
4.2 เส้นใยที่ไม่มีผนังกั้น (Nonseptate hypha or coencytic hypha)
การสืบพันธุ์ของสิ่งมีชีวิตในอาณาจักรฟังไจ
การสืบพันธุ์ของสิ่งมีชีวิตในอาณาจักรฟังไจ
1. Fragmentation เกิดจากเส้นใยหักเป็นส่วน ๆแต่ละส่วนเรียก oidia สามารถเจริญเป็นเส้นใยใหม่ได้
2. Budding การแตกหน่อ เป็นการที่เซลล์แบ่งออกเป็นหน่อขนาดเล็กและนิวเคลียสของเซลล์แม่แบ่งออกเป็น สองนิวเคลียส
นิวเคลียสอันหนึ่งจะเคลื่อนย้ายไปเป็นนิวเคลียสของหน่อ เมื่อหน่อเจริญเต็มที่จะคอดเว้าขาดจากกัน หน่อที่หลุดออกมาจะ
เจริญต่อไปได้ เรียกหน่อที่ได้นี้ว่า Blastosporeพบการสืบพันธุ์แบบนี้ในยีสต์ทั่วไป
3. Fission การแบ่งตัวออกเป็น 2 ส่วน แต่ละเซลล์จะคอดเว้าตรงกลางและหลุดออกจากกันเป็น 2 เซลล์พบในยีสต์บางชนิดเท่า
นั้น
4. การสร้างสปอร์แบบไม่อาศัยเพศ เป็นการสืบพันธุ์แบบไม่มีเพศที่พบมากที่สุด สปอร์แต่ละชนิดจะมีชื่อและวิธีสร้างที่แตก
ต่างกันไป เช่น
– condiospore หรือ conidia เป็นสปรอท์ที่ไม่มีเยื้อหุ้มเชลล์ (conidiophore) ที่ปลายของเส้นใย
จะมีเซลล์ที่เรียกว่า sterigma ทำหน้าที่สร้าง conidiaเช่น Aspergillus sp. และ Penicillium sp.
– sporangiospore เป็นสปอร์ที่เกิดจากปลายเส้นใยพองออกเป็นกระเปาะ แล้วต่อมามีผนังกั้นเกิดขึ้นภายใน กระเปาะจะมีผนัง
หนาและเจริญเป็นอับสปอร์ (sporangium) นิวเคลียสภายในอับสปอร์จะมีการแบ่งตัวหลาย ๆ ครั้งโดยมีส่วนของโปรโต
พลาสซึมและผนังหนามาหุ้มกลายเป็นสปอร์ที่เรียกว่า sporangiospore จำนวนมากมาย
5. การสืบพันธุ์แบบอาศัยเพศ มีการผสมมกันระหว่างเซลล์สืบพันธุ์และมีการรวมตัวของนิวเคลียส ซึ่งรวมแล้วเป็น diploid
(2n) และมีการแบ่งตัวในขั้นตอนสุดท้ายแบบ meiosis เพื่อลดจำนวนโครโมโซมลงเป็น haploid (n) ตามเดิม
การสืบพันธุ์แบบมีเพศในฟังไจ
แต่ละชนิดจะมีโครงสร้างที่เรียกว่า gametangium ทำหน้าที่สร้างเซลล์สืบพันธุ์เพศผู้และเพศเมียที่เรียกว่า gamete เข้าผสมกัน นอกจากนี้ยังพบว่าฟังไจที่มี gametangium สร้างเซลล์สืบพันธุ์เพศผู้และเพศเมียอยู่ในไมซิเลียมเดียวกันและสามารถผสมพันธุ์กันได้เรียกว่า monoecious แต่ฟังไจที่มี gametangium สร้างเซลล์สืบพันธุ์เพศผู้และเพศเมียอยู่ต่างไมซีเลียมกัน แต่ละไมซีเลียมเรียกว่า dioecious ในการสืบพันธุ์แบบมีเพศของฟังไจต่าง ๆ นี้
จะมีการสร้างสปอร์เกิดขึ้นเช่นเดียวกัน สปอร์ที่ได้จากการสืบพันธุ์แบบอาศัยเพศมีขนาดเล็กและจำนวนน้อยกว่า เช่น ascospore basidiospore zygospore และ oospore
การเจริญของฟังไจ
เส้นใยของฟังไจมีการเจริญได้สองทิศทาง ในตามขวางจะเจริญไปอย่างเต็มที่แล้วจึงหยุดเจริญ ส่วนการเจริญตามยาวของเส้นใยจะขยายยาวออกไปและแตกแขนงอย่างไม่จำกัดตราบเท่าที่สภาวะแวดล้อมยังเหมาะสม ฟังไจบางชนิดจะมีการเจริญเติบโตของเส้นใยที่มี เส้นผ่านศูนย์กลางมากกว่า 15 เมตร เส้นใยที่มารวมกันเป็นไมซีเลียมจะประกอบด้วยสองส่วนส่วนแรกเป็นไมซีเลียมที่ยึดเกาะกับอาหารเรียกว่า vegetative mycelium ทำหน้าที่ดูดสารอาหารไปเลี้ยงส่วนต่าง ๆ ส่วนที่สองเป็น ไมซีเลียมที่ยื่นไปในอากาศ เรียกว่า aerial mycelium หรือ reproductive mycelium ทำหน้าที่สร้างสปอร์เพื่อการสืบพันธุ์